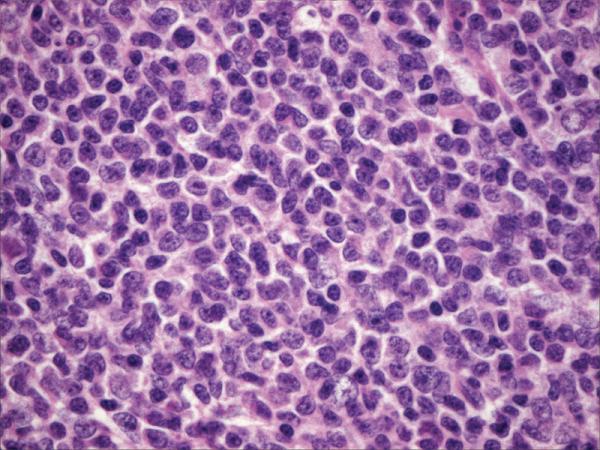

Mantle cell
Ча ча ча обучения
Сталкер nlc 3.0
Пихтовая 37 пермь
Интересные факты о истории древнего египта
Карта арсенал ключи
Образец страницы дневника
Самостоятельный маршрут по калининграду
Бизнес и экономика какая профессия
Песня пьехи нити на запястье
Шестой десяток это
Ткб 0111
Полярная звезда на небе карта
Сказки пушкина для детей 5 6
Mantle cell 114 фотографий